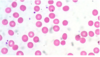

Fatigue Flashcards
(52 cards)
Ben Downer is a 50 y/o male who presents to his primary care physician for an annual visit and reports that he has been feeling tired for the past 2-3 months. What questions do you need to ask the patient about in order to further investigate a chief complaint of fatigue?
What does low energy mean to patient?
- Obtain a sleep history to determine if the patient is excessively sleepy during the day
- Inquire about weakness/loss of physical strength
- Explore if the patient has decreased exercise tolerance due to dyspnea on exertion
- Ask about mood symptoms
- Review medication list
- Review chronic medical conditions in past medical history that can cause fatigue
Pt comes in with complaint of fatigue: What findings will you be looking for on your physical exam of Mr. Downer?
• Pallor, tachypnea • BMI, neck circumference • Jaundice • Edema seen in CHF, CKD, and Liver disease • pulmonary rales, displaced PMI, S3, JVD • Coarse hair, “hung up” reflexes, weight gain • Rash, synovitis of joints • Fever, lymphadenopathy, heart murmur
Differential Dx for Fatigue
Psychiatric: depression/anxiety, substance use
Sleep disorder: OSA, insomnia
Endocrine: thyroid, DM, adrenal insufficiency
Medication Side Effects
Heme/Onc: anemia, cancer
Infections: HIV, endocarditis, TB, Lyme
Chronic Systemic Diseases of the Heart, Lung, Kidney, Liver, Neuro or Rheumatologic systems
Test you would order in pt with fatigue (within reason of course)
CBC • Sleep Study • BMP • LFTs • TSH and free T4 • Cortisol • Echocardiogram • Age appropriate cancer screening ie colonoscopy, mammogram • HgA1c • Pulmonary Function Tests • Rheumatoid factor, ANA, ESR/CRP • Chest Xray • Cortisol • HIV • Urine Drug Screen
- Fatigue means different things to different patients, thus:
- The differential diagnosis of fatigue is quite broad so a thorough history and physical exam needs to be performed on patients
clarify with the patient what they mean by this symptom during the history
Pt with coarse hair, ‘hung up reflexes’ and weight gain and fatigue should be worked up for:
hypothyroidism
Pt experiencing fatigue that has pallor and tachypnea should be worked up for
anemia
What are the DSM-V criteria used to make the diagnosis of depression?
5 or 9 for at least two weeks: must include depressed mood or anhedonia
SIGECAPS
Sleep disturbance, Interest loss, Guilt or worthlessness, Energy loss or fatigue, Concentration problems, Appetite or weight change, Psychomotor agitation or retardation, Suicidal ideation
is a chronic (2years+) low grade ie less than 5 of 9 symptoms depression
Persistent depressive disorder (dysthymia)
Things to consider when working up pt for depression
Ensure it isn’t depression due to general medical condition ie pancreatic cancer
- Ask about past manic episodes to assess for bipolar disorder
- Normal grief/bereavement needs to be distinguished from depression
A 31 y/o F presents c/o depression. Which of the following rules out the possibility of the patient having major depressive disorder?
A. She has recently gained weight
B. Her sleep pattern has changed so that she wakes up in the morning before her alarm rings
C. She reports being depressed since her miscarriage 2 years ago D. She was hospitalized for mania 10 years ago
E. She reports feeling like a worthless person
D. She was hospitalized for mania 10 years ago
• Distinct period of elevated, expansive or irritable mood and abnormally increased energy or activity lasting 1 week •
Symptoms include distractibility, irresponsible/hedonistic, grandiose, racing thoughts, psychomotor agitation, decreased need for sleep, pressured speech
Manic episode
How is hypmania different then mania?
• Hypomanic lasts 4 days, not impaired in functioning or psychotic, not hospitalized
Upon completing USMLE Step I a rising M3 runs out of the testing center shouting “I’m the smartest man in the world.” His roommate reports that for two weeks he has stopped sleeping, been quite irritable and talks incessantly. He is brought in for evaluation after attempting to use his student loan money to buy a lamborghini. Which of the following is the most likely diagnosis?
A. Amphetamine intoxication
B. Bipolar disorder
C. Hyperthyroidism
D. Schizophrenia
B. Bipolar disorder given that the student meets criteria for a manic episode
Whats is normal grief?
minor wt loss, minor sleep disturbance, milk guilty feelings, illusions or thinking you see loved one in a crowd, attempts to return to work, Crying, symptoms resolve in months to few years, don’t need anitdepressants
Complicated grief or depression
sigfnificant wt loss and sleep distrubance, intentse feelings of guilt, hallcucinations or delusions, resumes few if any activities, contemplates suicide, is disabled, antidepressants are indicated
Your 75 y/o male patient just lost his wife of 52 years to cancer. If he experiences normal bereavement/uncomplicated grief which of the following responses would be normal?
A. Initial loss of appetite with mild weight loss
B. Feelings of worthlessness
C. Threatening suicide
D. Intense disabling grief for next 2 years
E. Feelings of hopelessness
A. Initial loss of appetite with mild weight loss
You dx pt with a major depressive therapy and plan to start phamacotherapy.. what musst oyu discuss with pt and document in your note?
- The worst possible clinical outcome in depressed patients is completed suicide
- Despite having identified many epidemiologic risk factors, suicide remains difficult to predict
- Asking about suicidal ideation will not increase a patient’s risk or “give them the idea”
- Failure to assess and document suicide risk assessment represents a significant malpractice risk
What are risk factors associated with suicide?
Sex male (Caucasian at higher risk) Age teenagers or elderly Depression, Previous suicide attempts in patient or family hx, Ethanol or other drug use/addiction or impulsivity, Rational thinking absent, command hallucinations. Sickness, chronic medical condition or pain, 3+med,s Organized plan with means ie has a gun No spouse ie divorced, widowed, Social support lacking, no children or church or job
ou call the sheriff to place your schizophrenic patient on an emergency detention and the police officer tells you he has been feeling suicidal. Which statement encapsulates the highest risk factor for suicide completion? A. His wife just left him on account of his drinking B. He is an atheist with a gun C. He is a 60 y/o male police officer D. He is feeling hopeless about his prostate cancer E. He still walks w a limp after jumping off a bridge last year and you can see noose marks on his neck from his attempted hanging last week
He still walks w a limp after jumping off a bridge last year and you can see noose marks on his neck from his attempted hanging last week
Cross factors to consider when woriking up depression
• Cost/Insurance formulary • Ease of administration/dosing frequency • Side effect profile • Potential Drug interactions • Co-morbid medical conditions • Other approved drug indications that may apply to your patient • Toxicity in overdose in suicidal patients • Drugs used by family members
Fluoxetine, sertraline, paroxetine, citalopram, escitalopram, fluvoxamine
SSRIs, block 5-HT reuptaked; takes 4-6 wks
Uses, sides od SSRIs
Depression, anxiety disorders, bulimia
Side effects/Toxicity Nausea/vomiting, sexual dysfunction, risk of Serotonin Syndrome
What is Sererotin syndrome
- Symptoms include high fever, autonomic instability, seizures, confusion, myoclonus, flushing, treated with cyproheptadine
- May result from combining SSRI with MAOI or TCA or SNRI or meperidine or tramadol or St John’s Wort